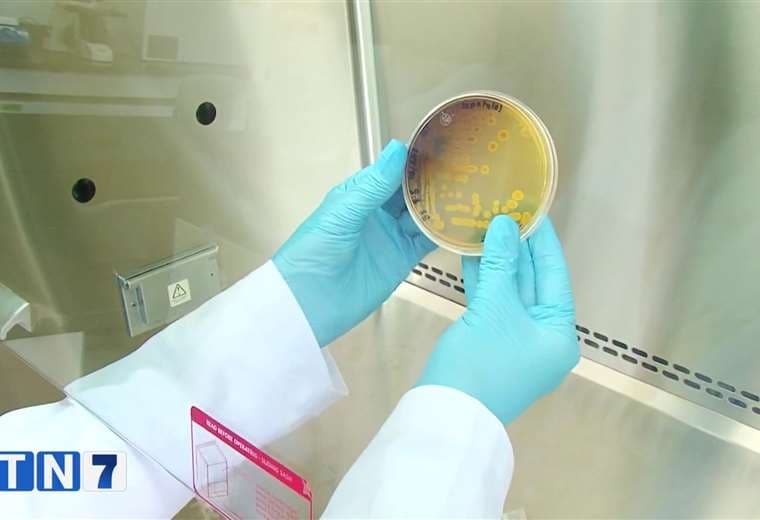

Costa Rica contará con prueba PCR para detectar viruela del mono
Los resultados de las pruebas tardarán entre cinco y seis horas.
Costa Rica ya no tendrá que enviar muestras al Centro de Control y Prevención de Enfermedades, ubicado en los Estados Unidos, para identificar posibles casos de viruela del mono.
Gracias a al apoyo de la Organización Panamericana de la Salud (OPS), el país contará con la prueba PCR en tiempo real cuyos resultados tardarán de 5 a 6 horas, así lo informó el ministerio de Salud.
El ministerio de Salud descartó, este viernes, el caso que se investigaba por sospechas de viruela del mono.
Las autoridades informaron que analizaron el paciente con una prueba que se utiliza para otra enfermedad pero que si logra identificar la familia a la que pertenece la viruela del mono
El resultado fue "enterovirus" un virus que provoca síntomas similares a los de la influenza
Tras descartar el caso, el país continuará con la estricta vigilancia.
La letalidad de la viruela del simio afortunadamente es baja y existe muchas formas de tratarla.